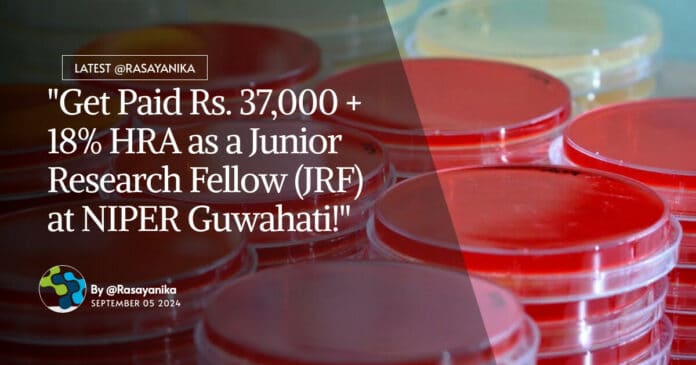

NIPER Pharma JRF Vacancy – Apply Online Now
NIPER Pharma JRF Vacancy – Apply Online Now. Interested and eligible applicants can check out all of the details on the same below:
Advt. No: NIPERG/Project-Rectt./2024/3 Dated: 28.08.2024
National Institute of Pharmaceutical Education & Research, Guwahati (NIPER-G) is an autonomous institute of National importance and the first national pharma institute in NE India set up by the Department of Pharmaceuticals, Ministry of Chemicals & Fertilizers, Govt. of India by an act of parliament, to impart high quality Education & Research in the area of Pharmaceutical Sciences. The Institute intents to fill the following Project position in CCRAS sponsored project through Online/ Physical Interview:
| Name of the Position, Fellowship, and Number of Position(s) | Name of the Sponsoring Agency/ Project / GAP Code | Qualifications and Experience | Max. Age Limit |
|---|---|---|---|
| Junior Research Fellow (JRF) Rs. 37,000/- + 18% HRA 1 (One) position |
CCRAS sponsored project entitled “Development of Quality standards of Elsholtzia Species and Assessment of Efficacy in Gastric Inflammatory Conditions (in vitro and in vivo studies)” in collaboration with RARC-Dimapur | Essential:
The candidate must have an M.S./M.Pharm. degree in Medicinal Chemistry/Natural Products/Pharmaceutical Analysis from a PCI/AICTE/UGC/NAAC recognized/accredited University/Central Autonomous Institutes with 60% marks or above. The candidate must have cleared GPAT/GATE/CSIR-NET or any National entrance test exam conducted by any Central Govt. agency at the time of the interview/selection process. Desirable: Candidates should have experience in natural product isolation and characterization using various analytical techniques like NMR, MASS, and other spectrometric techniques. He/she should be well-versed with various chromatographic techniques, natural product inspired synthesis of various compounds, molecular modeling, and drug designing. |
32 years as on the last date of application, relaxable up to 5 years in the case of SC/ST/OBC, physically handicapped and women applicants |
General Instructions:
- Candidates of Indian Nationality can only apply for these posts.
- Interested candidates are invited to apply using the prescribed format only, available on the website (www.niperguwahati.ac.in) from 28.08.2024 to 12.09.2024. It is mandatory to fill the application online and no other form of application will be entertained. Candidates are requested to arrange the softcopies of all the required documents before filling the application.
- Candidates should read carefully the requisite minimum essential qualifications, age and eligibility, experience criteria etc. laid down in the advertisement before applying for the above post. Since all the applications will be screened on the basis of data submitted by the candidate in the online application form, the candidates must satisfy themselves of the suitability for the position to which they are applying. If at any stage during the recruitment and selection process, it is found that candidates have furnished false or wrong information, their candidature will be rejected.
- Application once submitted cannot be altered / resubmitted, under any circumstances. Further, no request with respect to making changes in any data/ particular entered by the candidate in the application will be entertained, once the application is submitted successfully by email.
- Incomplete application or those without relevant supporting documents (Self-attested copies of Date of birth/Degrees/ Certificates/ Mark sheets/Experience Certificates/documents, etc.) will be rejected.
- On the recommendation of the Screening/Selection Committee, the competent authority may relax all or any of the requirements related to age and experience in exceptionally meritorious cases.
- Fulfilment of qualifications and experience is an essential requirement. As stated, the Institute is free to set the benchmark and call only the eligible candidates for the on-line interview. Further, NIPER Guwahati also reserves the right NOT to fill any of the post advertised, in the event or exigency so decided.
- Intimations will be sent only by E-mail/host on the website as per the details mentioned in the Application form.
- In case any dispute arises on account of interpretation of clauses in any version of this Advertisement other than English, the English version available on the NIPER-G Website shall prevail.
- CANVASSING IN ANY FORM MAY LEAD TO CANCELLATION OF THE CANDIDATE.
- All appointments shall be on contract for one Year and may be extended for another two years based on the performance of the candidate as well as availability of the funds and tenure of the project. The appointments are against the temporary project positions and will not continue in any circumstances beyond the duration of the said project. Any subsequent contract in the project or another project will be fresh appointment. The appointment in the outside funded project does not give project staff any claim whatsoever for appointment/regularization against any Institute post.
- Age will be calculated as on the last date of application i.e., 12.09.2024.
- List of the Shortlisted candidates will be displayed on the Institute website.
- Candidates are suggested to attend the interview physically. In-case if any candidates are unable to attend physically, such candidates may attend online interview, the link for the same will be sent to the shortlisted candidates individually, a day before the interview.
Keywords: NIPER Guwahati, Junior Research Fellow, Pharmaceutical Sciences, CCRAS sponsored project, Medicinal Chemistry, Natural Products, Molecular Modeling, Drug Designing. NIPER Pharma JRF Vacancy – Apply Online Now. Subscribe to Rasayanika for the latest chemistry and Pharma job openings, follow us on Facebook and Telegram and subscribe to our youtube channel for the latest updates on chemistry and Pharma jobs and much more.